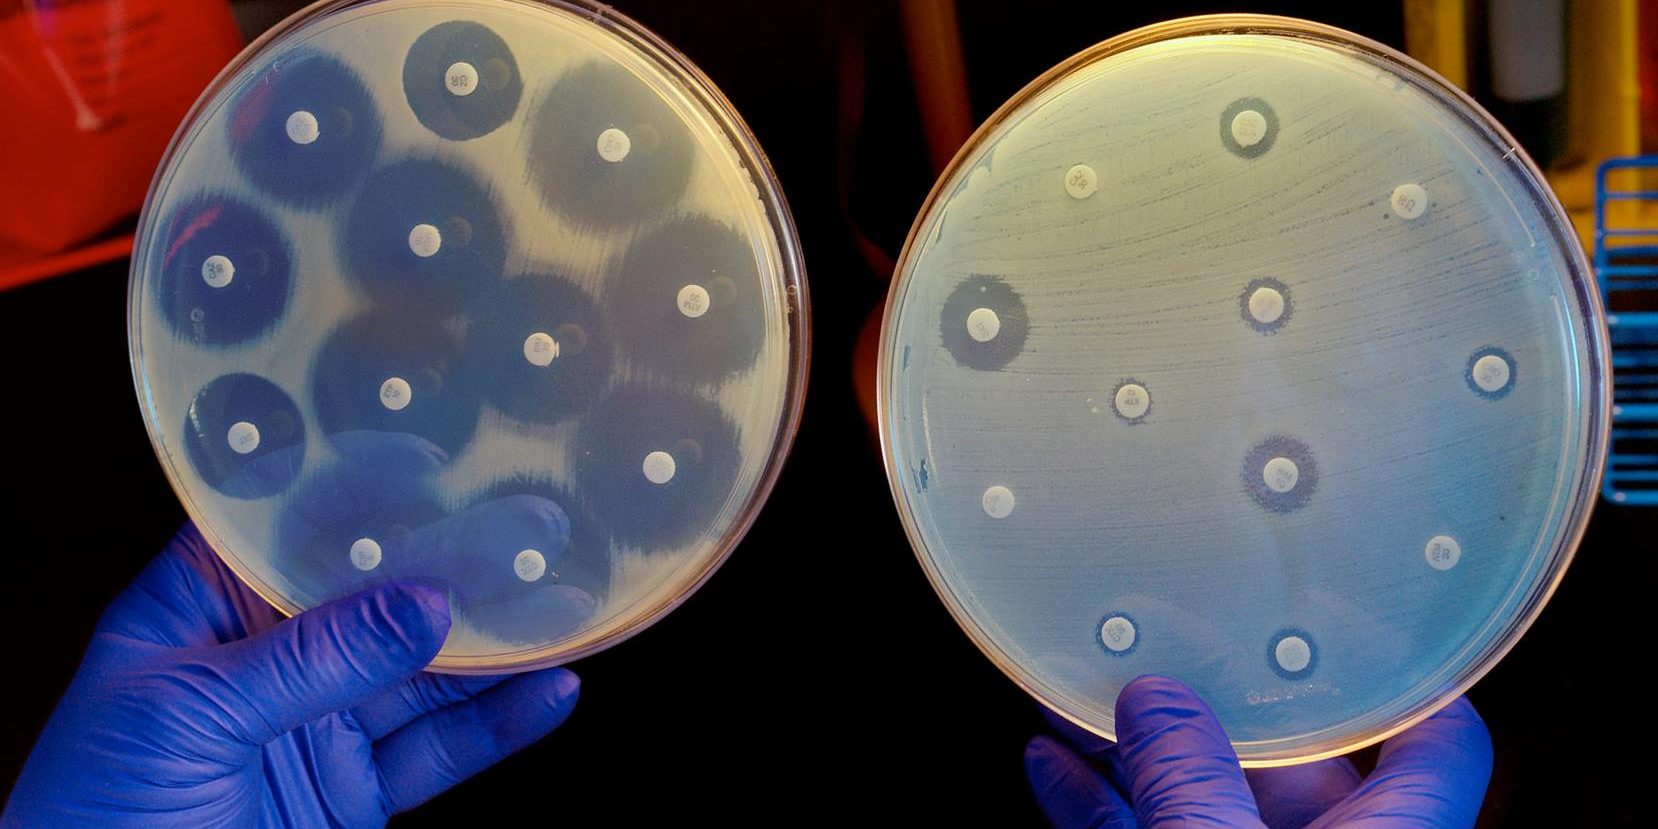

L’immagine che vedete fa vedere dei batteri “coltivati”: i dischetti contengono diverse molecole di antibiotico. Più è grande l’alone vuoto intorno, più il farmaco è efficace. Nella piastra sulla destra sono cresciuti batteri resistenti, che riescono a sopravvivere anche nelle immediate vicinanze di un farmaco che dovrebbe ucciderli. Immaginate di avere una polmonite, prendere un antibiotico e anziché migliorare, continuate a stare male e addirittura peggiorate. Ecco, questa è l’antibiotico-resistenza. I numeri sono questi: nella Unione Europea, ogni anno 4 milioni di pazienti contraggono un’infezione resistente agli antibiotici. Di questi, circa 25.000 muoiono.
Abbiamo solo un modo per evitare che questo accada. Usare gli antibiotici con CRITERIO. Questo vuol dire:
– non assumete antibiotici di cui siete già in possesso (leggi punto successivo) a random al primo mal di gola
– non interrompete la terapia al primo miglioramento dei sintomi (le confezioni degli antibiotici contengono compresse o bustine del numero giusto per terminare la terapia).
– non gettate gli antibiotici nella normale immondizia, o gli sciroppi antibiotici per bambini nel water: li disperdete nella natura, e diluendosi diventano perfetti per selezionare specie resistenti. I farmaci non usati vanno sempre smaltiti correttamente, riportandoli in farmacia o gettandoli nell’apposito contenitore dei farmaci scaduti.Quando nel nostro corpo circola un antibiotico al dosaggio sbagliato, o quando non c’è una reale infezione batterica da combattere, succede che molti batteri muoiano, mentre altri “miracolosamente” si “selezionino”, si salvino. Questo vuol dire che al prossimo giro di antibiotico, non subiranno alcun effetto. Ad esempio, tra i batteri resistenti più temibili ci sia proprio l’Escherichia Coli, che vive normalmente nel nostro intestino: ci stiamo talmente imbottendo di antibiotici che stiamo pian piano trasformando i nostri amici nei nostri nemici.
Fonte: Massimiliano Bellisario